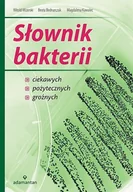
Książki medyczne - Słownik bakterii - miniaturka - grafika 1

Nauki ścisłe, medycyna

Podstawy Przyrostowe i Ekologiczne Odnawiania oraz Pielęgnacji Drzewostanów
ostatnia znana cena 65,99 zł

Geriatria i pielęgniarstwo geriatryczne. Podręcznik dla studiów medycznych
ostatnia znana cena 113,63 zł

Medipage Wydawnictwo Medyczne Kompendium leczenia złamań KOMPLET Tom I-II
ostatnia znana cena 310,00 zł

Reaktory chemiczne. Reaktory do układów heterogenicznych płyn-płyn oraz ciecz-ciało stałe
ostatnia znana cena 20,00 zł

Wydawnictwo Lekarskie PZWL Położnictwo i ginekologia Tom 1-2 - Grzegorz Bręborowicz
ostatnia znana cena 190,00 zł

Medyk Chemia Zbiór zadań dla liceum ogólnokształcącego i technikum zeszyt 13 Poziom rozszerzony
ostatnia znana cena 33,84 zł